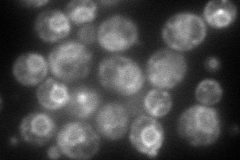
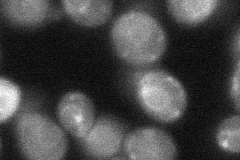
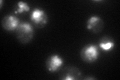

View description
Squalene epoxidase, catalyzes the epoxidation of squalene to 2,3-oxidosqualene; plays an essential role in the ergosterol-biosynthesis pathway and is the specific target of the antifungal drug terbinafine
Localization:
Intensity:
Fold change:
Significance:
-
C’ GFP library in SD

ER:punctate137.3 -
N' NOP1pr-GFP in SD
ER,punctate133.924 -
N' TEF2pr-mCherry in SD

ER,punctate61.6868 -
N' NATIVEpr-GFP in SD

ER,punctate75.8276 -
N' TEF2pr-VC and Cyto-VN in SD
ER,punctate39.5521 -
C’ GFP library in SD+DTT

ER.punctate131.950.96No -
C’ GFP library in SD+H2O2

ER.punctate178.051.29No -
C’ GFP library in Starvation Media
ER,punctate246.991.79Yes -
C’ GFP library on the background of Pup2-DaMP

ER:punctate -
C’ GFP library on the background of CCT mutant

ER:punctate149.5641.08925No
